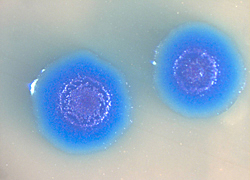
El primer trasplante de un genoma completo de una bacteria hacia otra bacteria

-
El programa de secuenciación del genoma de la levadura iniciado por la Unión Europea a principio de esta década y al que se unieron después otros países ha culminado con éxito.
-
Un pequeño gusano de nombre horrísono y grácil apellido, Caenorhabditis elegans, ha ganado la carrera de los genomas animales. Un consorcio internacional de científicos ha logrado, tras ocho años de lento trabajo y veloz imaginación, descifrar la totalidad de su material genético
-
Se dio la publicación del primer borrador del genoma humano el cual se venía trabajando con el objetivo de determinar la secuencia de pares de bases químicas que componen el ADN.
-
Se dio a conocer que el genoma humano, es decir, la secuencia de ADN esta compuesto por 3000 millones de pares de base con 25000 genes codificantes
-
El cromosoma único y circular del Mycoplasma mycoides fue trasplantado a un pariente lejano, el Mycoplasma capricolum.
-
Craig Venter fue capaz de sintetizar completamente el ADN de una bacteria pero no se ha logrado crear un organismo vivo artificial aún.
Looking for a timeline maker?
Create timelines for projects, roadmaps, history, lessons, legal cases, and stories with Timetoast. Timetoast is a timeline maker for work, school, research, and stories.